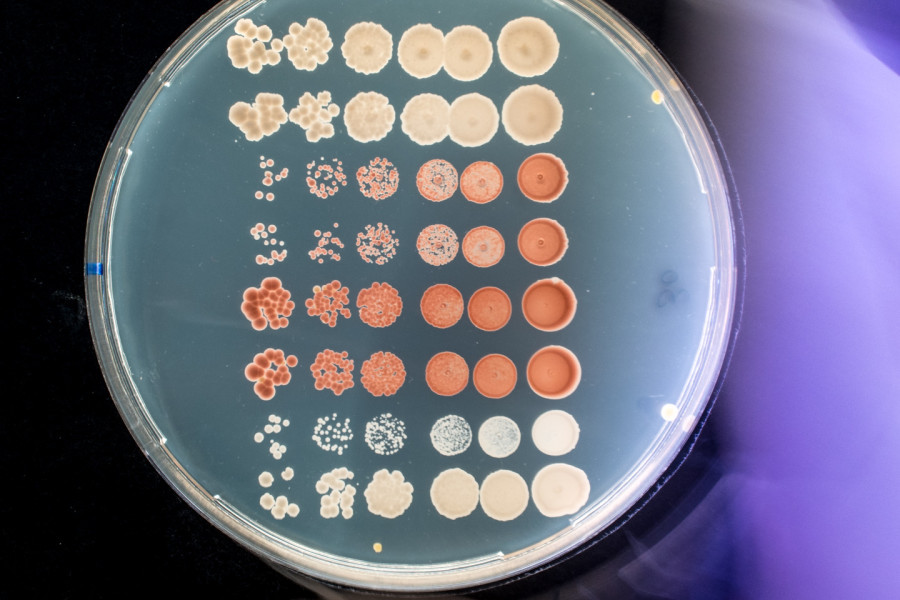
image Prise de vue

Prise de vue
Vous souhaitez valoriser des acteurs de la science, une expérimentation, des équipements, des préparations, des échantillons, des résultats …. SCIENCEIMAGE vous propose des solutions adaptées pour élaborer vos supports pédagogiques, documentaires ou autres.
Nous pouvons réaliser vos prises de vues photographiques ou vidéo à caractère scientifique afin de vous permettre de faire connaître vos travaux auprès d’un public spécialisé (de l’édition, de la documentation et de l’enseignement) ou du grand public.
Nous pouvons intervenir dans des laboratoires, en extérieur ou autre en fonction de vos besoins Télécharger le flyer.
Fonction illustrative
Fonction d'accès à la culture scientifique
Fonction informative
Fonction argumentative
Questions fréquentes
ScienceImage s'adresse aux chercheurs, ingénieurs, doctorants, équipes de recherche et directions de laboratoire souhaitant documenter, valoriser ou diffuser leurs travaux à travers des images fixes ou animées.
ScienceImage peut réaliser :
des prises de vue photographiques (expériences, instruments, gestes scientifiques, portraits),
des captations vidéo (protocoles, démonstrations, dispositifs expérimentaux),
des images macro ou micro, selon les contraintes techniques,
des captations en environnement contrôlé (salles blanches, laboratoires confinés, plateformes techniques).
Les productions peuvent être destinées à :
la communication scientifique (articles, posters, rapports),
la valorisation et la médiation auprès du grand public,
la diffusion institutionnelle (sites web, réseaux sociaux, expositions),
la documentation interne ou la traçabilité de protocoles.
La demande se fait en contactant ScienceImage :
une description du projet scientifique,
les objectifs de la prise de vue,
le contexte de diffusion envisagé,
les contraintes du laboratoire (sécurité, confidentialité, accès).
Un échange préalable permet d’évaluer la faisabilité et de définir le dispositif le plus adapté.
Oui. L’utilisation des images est encadrée par :
des droits d’auteur,
des droits à l’image des personnes filmées ou photographiées,
des règles de confidentialité et de propriété intellectuelle liées aux recherches en cours.
Les modalités sont précisées avant la réalisation.